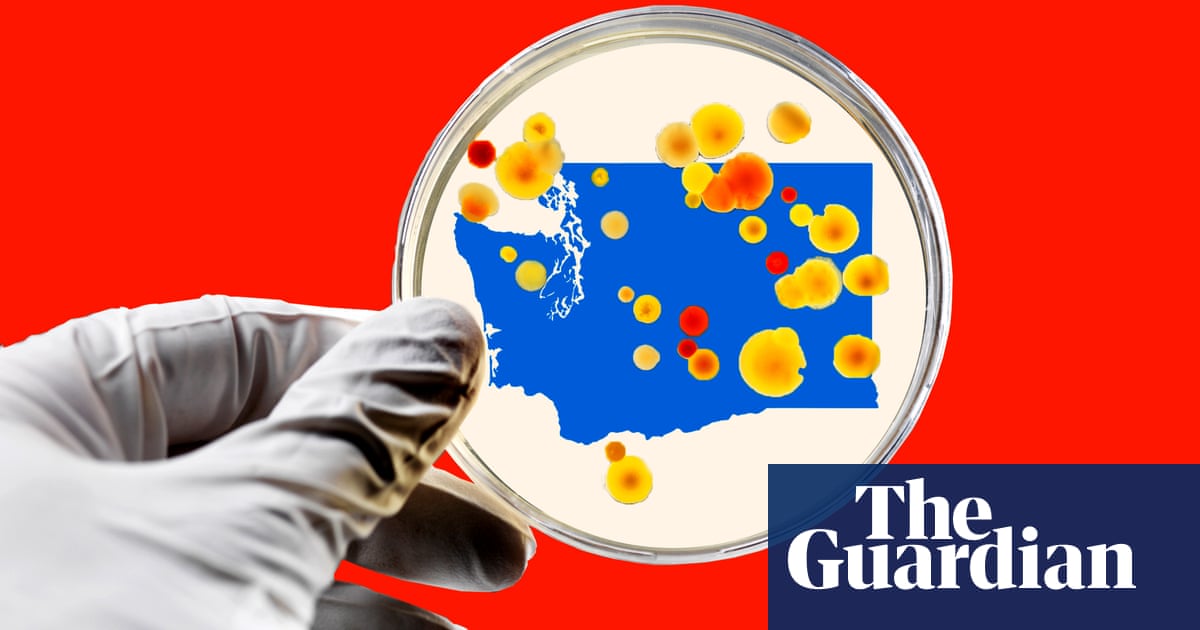

High numbers can be attributed in part to the fact that the state reported the first case in the US and jumpstarted testing
On Saturday, Alexandria, 22, was struggling to breathe, so she called 911 and was rushed to an isolation unit at a Seattle hospital.
She had had a fever for days and was tested for the flu and strep throat, and given a chest X-ray. But, she said, the doctors told her she would not be tested for coronavirus because she hadnt traveled to China and was not in the at-risk age range.
After being discharged with a diagnosis of a viral infection, with no recommendations about home isolation, she was escorted out of the hospital, where she waited on the street for her partner to pick her up.
It took four days before another physician heard her symptoms, sent her in for coronavirus testing, and she was diagnosed positive.
Since January, when Washington reported the first case of coronavirus in the US, the state has been the central focus of the American outbreak, documenting the most cases and deaths associated with the infection in the country. Its position in what has now been declared by the World Health Organization as a pandemic can be attributed to everything from individual missed opportunities for diagnosis and state funding gaps to restrictive federal guidelines for testing.
But at the same time, those high numbers can also be attributed to the simple fact that the state diagnosed its first case before the rest of America and was forced to jumpstart its testing and surveillance response.
Dr Scott Lindquist, the Washington state epidemiologist for communicable disease, explained that Washington is not at the countrys center of this outbreak, but rather at the leading edge.
We are leading the rest of the country, he said. They are using all our experience as theyre finding the same amount of activity in their state.
As of Thursday, state officials have confirmed 457 cases in Washington across 13 counties, including 31 deaths.
Following guidelines from the federal Centers for Disease Control and Prevention (CDC), early testing in Washington was done through the CDC and limited to individuals who had symptoms and a travel history to China or contact with a known case. These guidelines have since broadened, allowing academic and corporate labs to conduct testing and healthcare providers to decide who is eligible for the test.

Janet Baseman, the associate dean for the University of Washingtons School of Public Health, said she doesnt think theres anything that could have been done differently at the state and local level, as officials were following the federal guidelines. But if there had been more people tested earlier it could have had an important impact on exposure.
We would have found the cases earlier, and if we would have found the cases earlier, people who tested positive would have been able to take extra precautions to isolate themselves and to possibly keep other people from becoming exposed, thereby limiting transmission, she said.
The University of Washingtons virology lab was one of those spaces that was prepared early to contribute to additional testing. Keith Jerome, the head of the virology division at Fred Hutchinson Cancer Research Center, said developed a test that detects the virus and worked with the federal Food and Drug Administration (FDA) through February to get approval to start testing.
But the lab wasnt able to start until 2 March, after the FDA changed its policy to say labs that have validated tests could begin testing immediately.
The University of Washington lab can currently handle about 1,000 samples a day, and by next week may be able to process as many as 4,000 samples. Jerome said theyre working toward being able to test 10,000 samples a day, but also to simply get the word out that there are labs with plenty of capacity for testing.
According to the CDC website, between 18 January and 10 March, the highest number of samples collected for testing in a single day was 404.
Jerome said right now its not a priority to look at how the situation should or could have been handled, since they need to focus on responding to the outbreak at hand. But, in the future, when officials do take a careful look at how the outbreak developed, he said its very possible that theyll determine that more people should have been tested sooner.
He said its also possible they conclude that we should have tapped into the tremendous expertise that certain academic laboratories have in this kind of thing. To kind of keep them out of the response in the early days may not have been the right decision.
But the factor that may have truly solidified the states central position in the outbreak of coronavirus in the US was when the infection struck an acute nursing home in Kirkland, Washington, on the outskirts of Seattle.
Although most coronavirus infections cause mild symptoms, for people older than 60 years and those with chronic illness or weakened immune systems, it can cause more severe issues.
Over the last three weeks, the facility has seen
Washington states health department said Saturday that 18 CDC employees had been at the facility, and they along with Seattle and King county public health have provided technical assistance to the centers staff. The department said it has also provided the facility with an infection control expert, and there is a team of clinicians on site from the US health and human services department.
The states health department has spent $3.4m on coronavirus response. Lawmakers are currently in the process of approving $200m to go toward fighting the outbreak.
Lindquist said the public health system in Washington has been severely underfunded for years. If the funds theyve requested in the past had been approved and in place at the start of this outbreak, they would have been more prepared to handle it.
For example, during the 2019 legislative session, local health partners advocated for $100m in ongoing funding to support activities in such areas as communicable disease. The final budget included $22m in funding, according to the state health department.
I think we would have had more people working here, so we could have processed things with the latest technology instead of having to upgrade as were going along in this, he said. We would have had enough machines to do this, we would have had enough staff to do this, we would have had enough epidemiologists to give help to the counties that were overly burdened.
Original Article : HERE ;
from AllAbout https://allabout.pw/why-washington-state-is-at-the-center-of-the-us-coronavirus-outbreak/
No comments:
Post a Comment